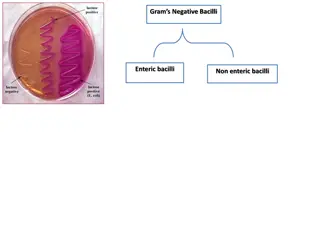

Antibiotics for Urinary Tract Infections: Mechanism, Pharmacokinetics, and Use
Urinary tract infections (UTIs) are common, with various bacteria causing the infection. Different groups of antibiotics are used to treat UTIs, each with its mechanism of action, pharmacokinetic properties, and adverse effects. Antibiotics such as Co-trimoxazole, Nitrofurantoin, and Cephalosporins are commonly prescribed. The rational combination of antibiotics targets specific pathogens, with Co-trimoxazole being a synergistic combination of Sulfamethoxazole and Trimethoprim. Understanding the spectrum of antibiotics can help in effective treatment of UTIs.
Download Presentation

Please find below an Image/Link to download the presentation.
The content on the website is provided AS IS for your information and personal use only. It may not be sold, licensed, or shared on other websites without obtaining consent from the author.If you encounter any issues during the download, it is possible that the publisher has removed the file from their server.
You are allowed to download the files provided on this website for personal or commercial use, subject to the condition that they are used lawfully. All files are the property of their respective owners.
The content on the website is provided AS IS for your information and personal use only. It may not be sold, licensed, or shared on other websites without obtaining consent from the author.
E N D
Presentation Transcript
Treatment of Urinary Tract Infection Editing File Recognize different groups of antibiotics used in UTIs . Describe their mechanism of action, pharmacokinetics properties and adverse effects. Describe the use of antibiotics and their rational of combination of different antibiotics. Describe the spectrum of various antibiotics.
Urinary Tract Infection (UTI) It is the 2ndmost common infection after RTI s. tcart yrotaripser( )noitcefni It is often associated with some obstruction of the flow of urine. Incidence of UTI increases in old age (10% of men & 20% of women). It is more common in women more than men 30:1 due to urethra in female shorter (4cm) Causes of UTIs Normally urine is sterile. Bacteria comes from digestive tract to opening of the urethra. Obstruction of the flow of urine(e.g. kidney stone) Enlargement of prostate gland in men(common cause( Catheters placed in urethra and bladder. Not drinking enough fluids. Waiting too long to urinate. Large uterus in pregnant women. Poor toilet habits(wiping back to front for women) Disorders that suppress the immune system (diabetes , cancer chemotherapy). Bacteria Responsible of UTIs Gm- bacteria (most common) Bacteria that also cause UTI Gm+ bacteria E.coli (approx. 80% of cases) Proteus mirabilis Klebsiella Pseudomonas aeruginosa Staphylococcus Saprophyticus (Approx. noomyenoh esuac sititsyc Mycoplasma, Chlamydia trachomatis aehrronog ot detimil( yam iloc.E ekilnu ,arhteru )dettimsnart yllauxes eb .N & ) 20% In general gram negative bacteria are more common causes of UTIs
UTIs can be Simple (uncomplicated) Complicated Infections Spread to other parts of the body and resistant to many antibiotics and more difficult to cure. {Due to hospital-acquired bacteria )E.coli,Klebsiella, Proteus, Pseudomonas, enterococci, staphylococci) Infections do not spread to other parts of the body and go away readily with treatment (Due to E.coli in most cases). Treatment of UTIs First we will do urine analysis to find the causative organism then choose the antibiotics according to it. Antibiotics: Co-trimoxazole (SMX/TMP) ), p.o. dna mirpohtemirt fo noitanibmoc( elozaxohtemaflus .) Nitrofurantoin, p.o. Tetracyclines, e.g. Doxycycline, p.o. Aminoglycosides, e.g. Gentamicin IV/IM Cephalosporins, e.g. Ceftriaxone & Ceftazidime IV 3rd gen most used because of their efficacy against gram -ve organisms Quinolones, e.g. Ciprofloxacin, p.o. p.o. = orally
Co-trimoxazole (Bactrim, Septra) combination of Sulfamethoxazole (SMX) - Trimethoprim (TMP) Alone, each agent is bacteriostatic Together they are bactericidals )synergism( This is the reason we combine the two drugs. The optimal ratio of TMP to SMX in vivo is 5 :)XMS( 1 *)PMT( ; 800 mg SMX+160mg TMP; 400 mg SMX+ 80 mg TMP; 40 mg SMX+8 mg TMP). *our FORMULATED dosage ratio is always giving sulfonamides 5 times more than Trimethoprim, our IN VIVO dosage is 1:20 Overview detalumrof ( 1:20 Mechanism of Enzymes requiring folate-derived cofactors are essential for the synthesis of purines and pyrimidines (precursors of RNA and DNA) and other compounds necessary for cellular growth and replication. Therefore, in the absence of folate, cells cannot grow or divide. And that is the mechanism of THE FOLATE ANTAGONISTS (Sulfamethoxazole + trimethoprim). The synergistic antimicrobial activity of cotrimoxazole results from its inhibition of two sequential steps in the synthesis of tetrahydrofolic acid. Sulfamethoxazole inhibits the incorporation of PABA into dihydrofolic acid precursors, and trimethoprim prevents reduction of dihydrofolate to tetrahydrofolate see next slide^_^ action Gastrointestinal- Nausea, vomiting Allergy Hematologic a) Acute hemolytic anemia Sulfonamide especially a) hypersensitivity b) G6PD deficiency b) Megaloblastic anemia due to TMP Drug interactions: Displace bilirubin- if severe kernicterus condition in which bilirubin accumulates in brain Potentiate warfarin causes bleeding, oral sulfonylurea hypoglycemics oral antidiabetic. Adverse effects . Pregnancy Nursing mother indication Infants under 6 weeks because it will cause displacement of bilirubin Contra- leading to jaundice Renal or hepatic failure Blood disorders eg Haemophilia because of risk of hemolytic anemia
Will block the first step of the DNA synthesis Will block the second step of the DNA synthesis Sulfamethoxazole (Sulfonamides) ( SMX) Trimethoprim ( TMP) Drug Usually given orally/IV, alone or in combination with SMX. Well absorbed from the gut. Widely distributed in body fluids & tissues ( including CSF ). More lipid soluble than SMX. Protein bound (approx. 40 ) % 60 % of TMP or its metabolite is excreted in the urine TMP concentrates in the prostatic fluid & vaginal fluids (> acidity than plasma). Mainly given orally (can be given IV in some cases) Rapidly absorbed from stomach and small intestine. Widely distributed to tissues and body fluids (including CNS, CSF ), placenta and fetus. Absorbed sulfonamides bind to serum protein (approx. 70% ) . Metabolized in the liver by the process of acetylation. Eliminated in the urine, partly as such and partly as acetylated derivative. Absorption, metabolism & Excretion
Nitrofurantoins Bactericidal for gm-ve & gm+ve bacteria Nitrofurantoin is effective against E.coli & Staph. Saprophyticus. Other common UT gram -ve bacteria may be resistant. So if we re sure one of the 2 organisms mentioned above is the causative organism of the UTI, we will use nitrofurantoin Antibacterial murtcepS Mechanism of Action Sensitive bacteria reduce the drug to an active agent that inhibits various enzymes and damages DNA. Complete and rapid oral absorption. 75 % metabolized & is excreted so rapidly that no systemic antibacterial action can be achieved. So that means nitrofurantoin is a poor choice in sytemic spreading infections because it does not stay long enough in the body to spread to the other infected areas. Concentrated in urine. (25% is excreted unchanged) Urine turns to dark orange-brown (harmless). Pharmaco- kinetics GI disturbances : Bleeding of the stomach Nausea Vomiting Diarrhea (Must be taken with food) Headache & Nystagmus(involuntary eye movements). Hemolytic anemia (G6PD Deficiency) Adverse Effects Contra- indications Patients with G6PD deficiency. Neonates. Pregnant women. (after 38 weeks of pregnancy) Used as urinary antiseptic. It s usefulness is limited to lower UTI s & cannot be used for upper UT or systemic infections. Because it has bad distribution in body. Dose: 50 - 100 mg, orally, 6h/7 days. Long acting: 100mg twice daily. Uses
Tetracyclines E.g. Doxycycline (Long acting tetracycline) Inhibit protein synthesis by binding reversibly to 30s subunit Against gm+ve & gm-ve bacteria. Mechanism of action Usually given orally. Absorption is food Absorbed in upper small intestines, best on an empty stomach. Food with these di & tri cations (Ca, Mg, Fe, Al) impair absorption. Protein binding 40 - 80 .% Well distributed, including CSF. Cross placenta, excreted in milk. Largely metabolized in liver. % 100 - 90 so given 3 hrs after or 2 hrs before Pharmaco- kinetics Nausea, vomiting, diarrhea, & epigastric pain (when give with food containing the mentioned impairing substances) Thrombophlebitis - I.V Hepatic toxicity (Prolonged therapy with high dose) Brown discolouration of teeth in children Deformity/growth inhibition of bones in children Phototoxicity Vertigo Superinfections (because they alter the intestinal flora due to broad spectrum activity) . Adverse effects Contra- indications Pregnancy Breast feeding Children below 10 years Treatment of UTI s due to Mycoplasma & Chlamydia. 100mg orally, bid (twice a day) for 7 days. Prostatitis. Uses
Aminoglycosides E.g. Gentamicin Bactericidal antibiotics. Given I.M or I.V. poorly absorbed orally (highly charged). Active against gm-ve aerobicsmsinagro Excreted unchanged in urine. More active in alkaline medium. Cross placenta. Pharmaco- kinetics Mechanism of action Inhibit protein synthesis by binding to 30S ribosomal subunits . Similar to tetracyclines Ototoxicity. Nephrotoxicity. Nerve damage Neuromuscular blocking effect. Adverse effects Only active against gram negative aerobic organism. Severe infections caused by gram negative organism )pseudomonas or enterobacter(. Uses
Cephalosporins Generation 1st 2nd 3rd Ceftriaxone, Cefotaxime, Cefixime, Ceftazidime Drugs Cephalexin Cefuroxime, Cefaclor Route of Administration Orally Well absorbed Orally I.V Gram-negative bacteria )Active against - lactamase - producing bacteria( Gram-positive bacteria Gram-negative bacilli Spectrum Mechanism of Action Inhibit bacterial cell wall synthesis Bactericidal )similar to Penicillins( Classified into 3 generations: Cephalosporins are given parenterally Relatively lipid insoluble (like penicillins). Don t penetrate cells or the CNS, except for third generations. Mostly excreted unchanged by the kidney (glomerular & tubular secretion). Probenecid slows their elimination & prolong their half lives( Half-life: 30 - 90 min; except ceftriaxone 3rd generation is more lipid soluble Pharmaco- kinetics 4 - 7 hr.) Hypersensitivity reactions. Thrombophilibitis. Inflammation of the wall of vein Superinfections. Because of killing of normal flora Diarrhea. *Dr. Aliah said: Local irritation can produce pain after IM injection & thrombophlebitis after IV injection. Adverse Effects severe/complicate d UTIs & acute prostatitis Effective in treatment of pneumonia Upper & lower RTIs Uses Effective in URTIs
Fluoroquinolones Drugs Ciprofloxacin Moxifloxacin Gatifloxacin Antibacterial spectrum G ve aerobic organism highly active against Pseudomonas species G ve & G+ve highly active against Pseudomonas species Mechanism of action Block bacterial DNA synthesis by inhibiting DNA Gyrase enzyme (an enzyme involved in DNA supercoiling.) Dose twice-daily once daily Given po or parenterally Concentrates in many tissues (kidney, prostate, lung & bones/ joints) it means it can treat infections in these organs. Excreted mainly through the kidney long Half-life Pharmaco- kinetics Nausea, vomiting and diarrhea CNS effects (confusion, insomnia, headache and anxiety) Damage of growing cartilage (arthropathy( inflammation of joint Phototoxicity (avoid excessive sunlight) cause skin irritation Adverse effects Contra- indications Not recommended for patients younger than 18 years Pregnancy Breastfeeding women UTIs caused by multidrug resistance organism as pseudomonas Prostatitis (acute/chronic) Clinical Uses
Questions 1. . greater than the individual drug effect? a-combination b-co-administration c-synergism d-drug interaction is when the sum of two drugs effect is 6. A patient with megaloblastic anemia should avoid .. ? a-gentamycin b-amoxicillin c-nitrofurantoin d-TMP 2. Managment of UTI mainly depends on a-NSAIDs b-Diuretics c-chemotherapy d-antibiotics ? ... 7. Patient with upper UTI should avoid using ? a-nitrofurantoin b-gentamycin c-amoxicillin d-quinolones 3. A patient with UTI was given co-trimoxazole drugs (sulfamethoxazole SMX/Trimethoprim TMP) if the doctor prescribed 40 mg of SMX then the formulated dose of TMP should be equal to . ? a-200 mg b-8mg c-4mg d-800mg 8. Doxycycline mechanism of action is inhibiting protein synthesis by binding to tinubus S. ? a-irreversibly /60 b-reversibly /60 c-irreversibly/30 d-reversibly/30 9. If Doxycycline given by IV it might cause ? a-heart burn b-thrombophlebitis c-Sydenham corrhea d - urine retention 4. Using the same data in question for if the SMX level in vivo is 20mg than TMP level should be . ? a-40ml b-4mg c-1mg d-400mg 10. Aminoglycoside are not active against? a-gram bacteria b-gram + bacteria c-viruses d- both b and c 5. Sulfamethoxazole alone is considered a-bacteriostatic b-bactericidal c-both d-no effect . ? each 5 mg of SMX: hemolytic an mia. LOWER UTI ONLY --------------------- TMP:20mg SMX. *remember: for ****WORK ON **in vivo 1mg A**** C*** 1mg of TMP. C** ***c: cause B* D D D A B C Answers: 10. 1. 2. 3. 4. 5. 6. 7. 8. 9.
Questions Case incomplete voiding, fever and prostatic pain biopsy showed gram- diplococci. 20 A : year old male patient came to clinic with spontaneous urethral discharge, 1. what is the causing organism? 2. what is the name of this disease? 3. what is the best drug for this case? 4. what is the route of administration for this drug? 5. what is the mechanism of action for this drug? 6. name 2 contraindications for this drug? 1. 2. 3. 4. 5. 6. neisseria gonorrhea. acute prostatitis . cephalosporin(ceftriaxone or ceftazidime). parental (I.V.). inhibition of cell wall synthesis (bactericidal). hypersensitivity and GIT problems.
Questions Case prescribed an antibiotic for her but she says the drug worked at first but the problem returned you did some lab test than you found out that her urine contained +Leukocytosis,culture showed aerobic, nonfermentative, non enterobacterial gram- negative bacilli and her ultrasound tests showed no anatomical problems. 58 year old lady told you that she have UTI and that her previous doctor : clinical presentation results : no signs of TB or pneumonia 1. causative organism? 2. what is the name of the antibiotic that was given by her old doctor? 3. why didn't the drug work? 4. what drug should you use in this case? 5. what is the mechanism of this drug? 6. name 2 side effect associated with this drug? 1. 2. 3. 4. 5. 6. pseudomonas. might be amoxicillin. because it is a multi drug resistance bacteria. ciprofloxacin. it inhibit DNA gyrase enzyme. phototoxicity and arthropathy (damage cartilage).
Questions Case: smelborp gniwollof eht morf gninialpmoc nemow tnangerP : burning sensation when voiding urine, urgency for peeing. lab test showed cloudy urine ,leukocytes + , bacteria count more than 100000per ml and urine culture showed Gram-negative, facultatively anaerobic, rod-shaped bacteria. 1. what is the problem? 2. what is the causative organism? 3. what is the best drug for this case? 4. what drugs should you avoid? 5. to prevent future infections should we use prophylaxis in this case? 1. 2. 3. 4. 5. cystitis. E.coli. amoxicillin ,penicillin and erythromycin. tetracyclines , SMX,TMP and Nitrofurantoin . yes we should continue with antibiotic one daily dose throughout the pregnancy period.
It is not hard, you just made it to the end ! Team Leaders: Yazeed Alharbi & Hadeel Awartani Sub Leader: khaled Aldosari Design: Omar alyabis Content Abdullah Alzahrani Fahad Alsaqer Yazeed Alkhayyal Mohammed nouri Notes: Anas Alsaif Nawaf Alsubaie Questions: Sultan omar Almalki References: Doctors notes and slides @Pharma4370 pharmacology moc.liamg@ 437